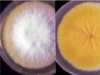
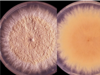
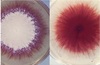
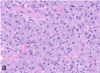
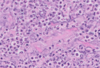

Fungal Infections Flashcards
(235 cards)
What do fungal PAMPs activate?
TLRs
- esp. TLR 2 and 4 for dermatophytes
NOD-like
C-type lectins (ex. mannose binding lectin)
- Dectin-1 binds to b-glucans and triggers IL-22/23
- Dectin-2 bind to α-mannans
- Dectin is on on mast cells too
Scavenger receptors
- DC-SIGN binds mannose
Malassezia cell wall carbohydrates are IgE binding epitopes with AD
- also have IgG and IgA produced (increased with more organisms)
What type of immune response is most important for destroying established fungal infections?
Th1
Th17 - esp for dermatophytosis and Malassezia
no correlation between circulating Abs and protection for dermatophytes
- believed cell-mediated immune response is most important
What are the predominant fungal genera identified on the skin surface of dogs?
Alternaria
Cladosporium
Epicoccum
variable proportions of Malassezia spp
- Malassezia globosa
- Malassezia restricta
- Malassezia pachydermatis (overgrows in inflamed skin)
What are the predominant fungal genera identified on the skin surface of cats?
Cladosporium
Alternaria
Epicoccum
What are the predominant fungal genera identified on the skin surface of horses?
Alternaria
Cladosporium
Fusarium
Aspergillus
Penicillium
Scopulariopsis
(many represent repeated transient contamination from the saprophytes)
Which breeds of cats have higher carriage rates of Malassezia spp, even in the absence of skin lesions?
Devon Rex and Sphynx cats
What is thought to be a primary reason for the increased number of fungal infections, especially opportunistic infections, in veterinary medicine?
higher number of immunosuppressed individuals being treated for cutaneous or systemic immune-mediated diseases or receiving chemotherapy treatment
What are the two stains most commonly used to identify fungus?
periodic acid-Schiff (PAS) reaction
- bright magenta hue
- will only identify living fungus
Grocott’s methenamine silver (GMS) stain
- black color
- more sensitive and will identify more things (including nonviable)
(Fungal cell walls contain polysaccharides that form aldehyde groups upon oxidation and can be detected by both stains)
If a fungal organism is cultured from the skin, what is important to confirm the pathogenic significance of the fungi?
fungal elements identified in the tissue
What are the typical histopathologic morphologic features of Malassezia?
3–8 μm peanut-shaped yeast
Located in superficial keratin and follicular ostia
PAS can be helpful
What are the typical histopathologic morphologic features of Candida?
can grow as yeasts, hyphae, and pseudohyphae simultaneously
3–4 μm ovoid yeast with single budding
Ellipsoid pseudohyphae with constriction at septae
Parallel-walled hyphae with regular septation
PAS can be helpful
What are the typical histopathologic morphologic features of dermatophytes?
2–3 μm wavy septate hyphae with parallel walls
2 μm arthrospores
Endothrix (inside) or ectothrix (outside/degrade cuticle)
- most geophiles and zoophiles are ectothrix
- most anthropophiles are endothrix
Can cause deep pseudomycetomas in Persian cats
PAS or GMS can be helpful
What are the typical histopathologic morphologic features of white-grain eumycotic mycetoma?
2–7 μm septate and nonpigmented hyphae
Infrequent dichotomous branching
Frequent 2–7 μm terminal cystic dilations
What are the typical histopathologic morphologic features of black-grain eumycotic mycetoma?
2–7 μm septate and pigmented hyphae
Infrequent dichotomous branching
Frequent 2–7 μm terminal cystic dilations
What are the typical histopathologic morphologic features of hyalohyphomycosis?
2–6 μm septate hyphae with parallel walls, occasional acute-angle branching
Up to 10 μm terminal bulbous swellings
4–12 μm yeast-like cells may be the only form
What are the typical histopathologic morphologic features of Aspergillus spp?
2–6 μm septate hyphae with parallel walls
Frequent acute-angle branching
What are the typical histopathologic morphologic features of mucorales?
Sparsely septate, 8–20 μm hyphae
Nonparallel walls and irregular branching
What are the typical histopathologic morphologic features of entomophthoromycosis?
6–20 μm (Basidiobolus), 5–12 μm (Conidiobolus) hyphae, sparsely septate
Nonparallel walls, rare irregular branching, terminal bulbous dilations
Eosinophilic sleeve around hyphae
What are the typical histopathologic morphologic features of phaeohyphomycosis?
2–10 μm pigmented hyphae ± branching with beaded appearance
4–15 or rarely 30–50 μm yeast-like forms
Fontana-Masson may highlight melanin
What are the typical histopathologic morphologic features of chromoblastomycosis?
10–20 μm pigmented Medlar bodies with transverse and longitudinal septation
What are the typical histopathologic morphologic features of oomycosis?
2–7 μm (Pythium) or 8–25 μm (Lagenidium)
Nonparallel walls, irregular branching, rare septae
Eosinophilic sleeve around hyphae
Will not stain with PAS
What are the typical histopathologic morphologic features of Blastomyces spp?
5–20 μm yeast
Double contoured wall
Broad-based budding
Yeasts are typically sparse
What are the typical histopathologic morphologic features of Histoplasma spp?
2–4 μm, round yeast
Clear halo, thin cell wall
Numerous yeasts within macrophages
GMS preferred over PAS
What are the typical histopathologic morphologic features of Cryptococcus neoformans and Cryptococcus gattii?
3.5–20 μm, oval yeast
Wide clear capsule resembling a “soap bubble”
Cutaneous lesions common in facial/nasal region (especially in cats)
Yeasts are typically numerous
Capsule highlighted by mucicarmine (or Alcian blue)